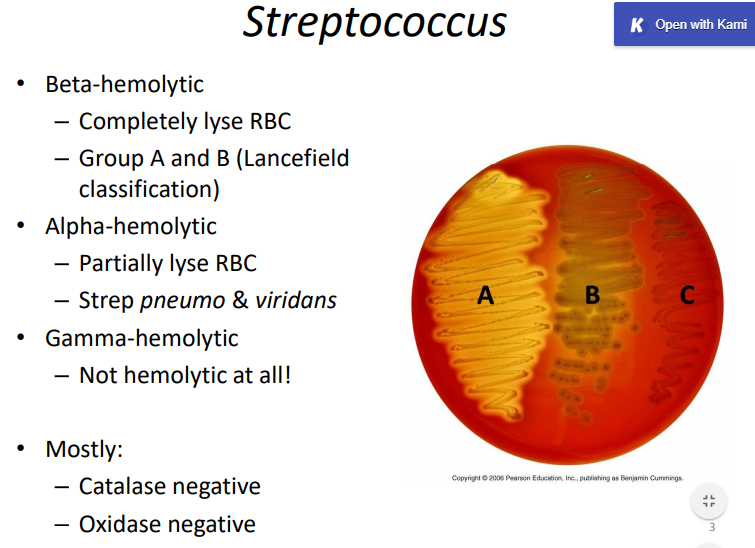

Beta-hemolytic organisms ____ lyse RBCs and include which 2 organisms?
Beta-hemolytic organisms completely lyse RBCs and include:

GAS = S. pyogenes
GBS = S. agalactiae
alpha-hemolytic organisms ___ lyse RBCs and include which 2 organisms?
alpha-hemolytic organisms partially lyse RBCs and include:
S. pneumo
S. viridans
gamma-hemolytic organisms ___ lyse RBCs and include which 2 organisms?
alpha-hemolytic organisms DON’T lyse RBCs and include:
S. enterococcus
S. bovis

which 2 organisms are PYR positive?
S. pyogenes and Enterococcus

M protein inhibits activation of ___ by binding ____ and protects {organism} against phagocytosis
M protein inhibits activation of complement by binding factor H and protects {S. pyogenes} against phagocytosis

what layers are affected in erysipelas vs. cellulitis?
erysipelas = upper dermis only
cellulitis = deeper dermis and subcutaneous fat

erysipelas is mainly caused by {organism}
erysipelas is mainly caused by {S. pyogenes}

list the 4 criteria in Centor criteria for Strep pharyngitis
exudate
cervical adenopathy
fever history
lack of cough

rheumatic fever follows only which infection?
ONLY pharyngitis (NOT skin infections)

in a suspected patient with strep pharyngitis, check ____ which detects ____ antigen
in a suspected patient with strep pharyngitis, check rapid antigen detection test (RADT) which detects A-carbohydrate antigen

what is Ludwig’s angina?
life-threatening infection of submandibular space, usually from dental infections with S. viridans

the main virulence factor of H. influenzae is its _____ which protects against lysis by binding ____
the main virulence factor of H. influenzae is its polyribitol phosphate (PRP) capsule which protects against lysis by binding factor H

type I necrotizing fasciitis is caused by ____
while
type II necrotizing fasciitis is caused by _____
type I necrotizing fasciitis is caused by polymicrobials
while
type II necrotizing fasciitis is caused by 1 organism (usually GAS)

Strep toxic shock is caused by which protein strains?
M1 and M3

which S. viridans groups are associated with dental infections and endocarditis?
Mitis group
Salivarius group
Mutans group

which S. viridans group is associated with a brain of GI abscess?
Strep intermedius and Anginosus

how do Enterococci species generate vancomycin resistance?
encodes peptidoglycan cell wall change: D-ala-D-ala –> D-ala D-Lac



